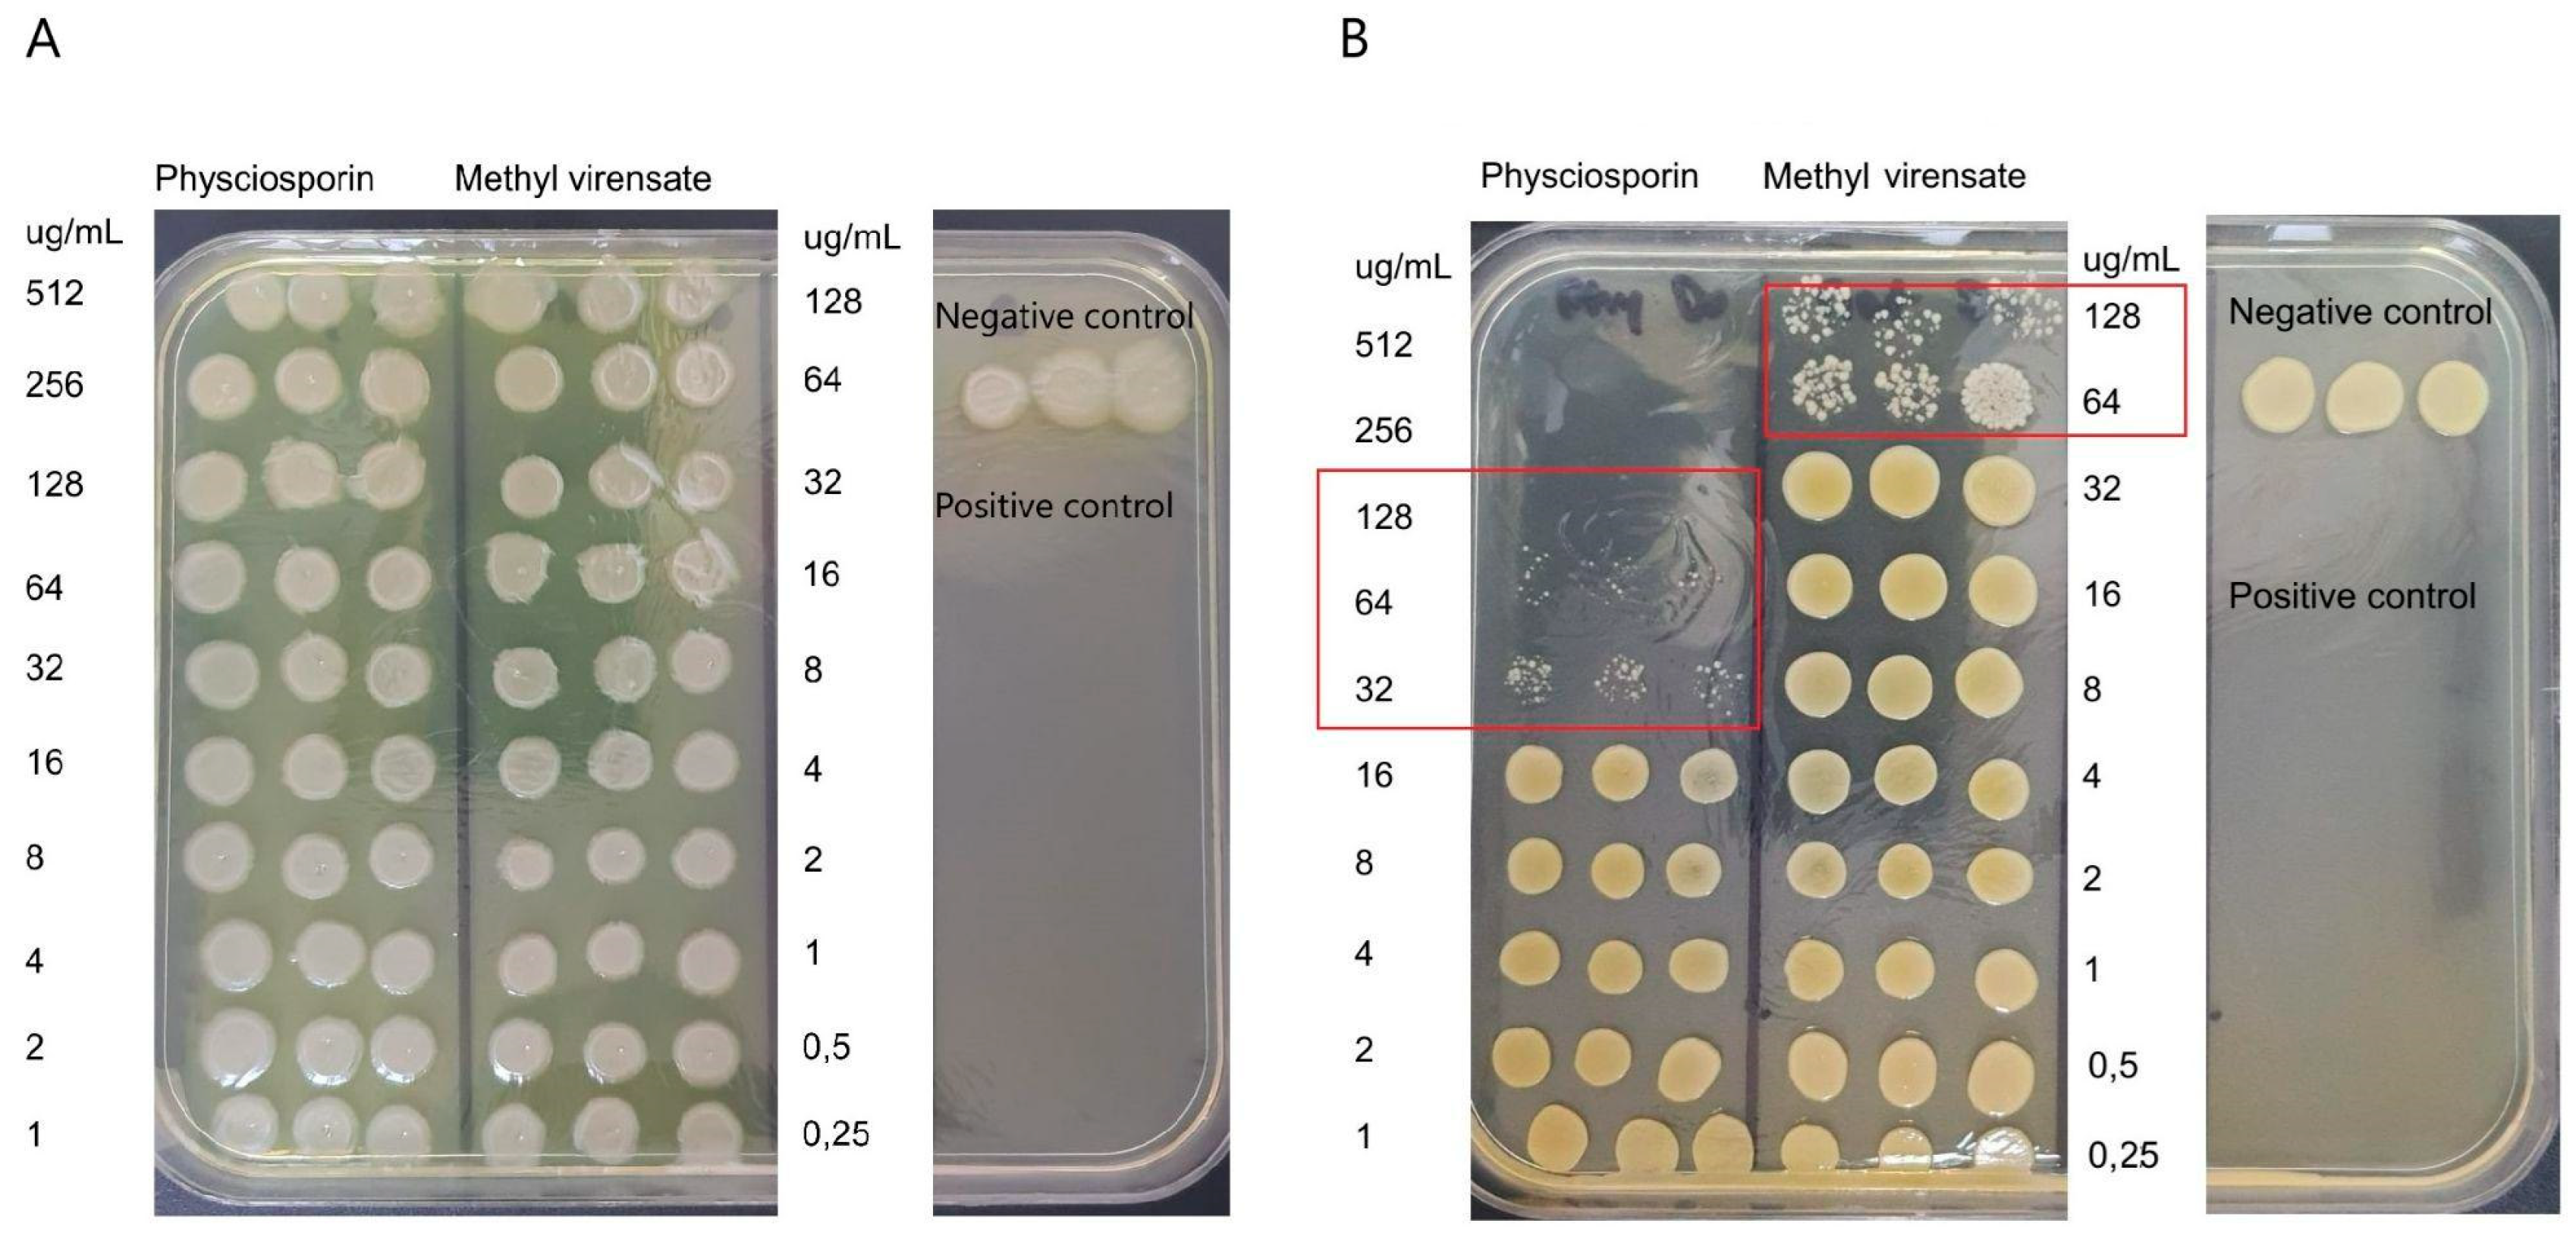

Isolation, Chemical Characterization, and Antimicrobial Activity of Secondary Metabolites from Pseudocyphellaria faveolata
Abstract
1. Introduction
2. Results
2.1. Chemistry
2.2. Antimicrobial Activity
2.3. Cell Viability
3. Discussion
Antimicrobial Activity of Physciosporin and Methyl Virensate
4. Materials and Methods
4.1. Lichen Material
4.2. Spectroscopic Analysis
4.3. Isolation of Compounds
4.4. Bacterial Culture
4.5. Determination of Minimum Inhibitory (MIC) and Bactericidal Concentration (MBC)
4.6. Determination of Antibiofilm Activity
4.7. Cell Viability Assay
5. Conclusions
Supplementary Materials
Author Contributions
Funding
Institutional Review Board Statement
Informed Consent Statement
Data Availability Statement
Conflicts of Interest
References
- Tacconelli, E.; Carrara, E.; Savoldi, A.; Harbarth, S.; Mendelson, M.; Monnet, D.L.; Pulcini, C.; Kahlmeter, G.; Kluytmans, J.; Carmeli, Y.; et al. Discovery, research, and development of new antibiotics: The WHO priority list of antibiotic-resistant bacteria and tuberculosis. Lancet Infect. Dis. 2018, 18, 318–327. [Google Scholar] [CrossRef]
- Jesudason, T. WHO publishes updated list of bacterial priority pathogens. Lancet Microbe 2024, 5, 100940. [Google Scholar] [CrossRef] [PubMed]
- Flemming, H.-C.; Wingender, J. The biofilm matrix. Nat. Rev. Microbiol. 2010, 8, 623. [Google Scholar] [CrossRef] [PubMed]
- Bjarnsholt, T. The role of bacterial biofilms in chronic infections. APMIS Suppl. 2013, 136, 1–51. [Google Scholar] [CrossRef] [PubMed]
- Rabin, N.; Zheng, Y.; Opoku-Temeng, C.; Du, Y.; Bonsu, E.; Sintim, H.O. Biofilm formation mechanisms and targets for developing antibiofilm agents. Future Med. Chem. 2015, 7, 493–512. [Google Scholar] [CrossRef]
- Gyawali, R.; Ibrahim, S.A. Natural products as antimicrobial agents. Food Control. 2014, 46, 412–429. [Google Scholar] [CrossRef]
- Wang, G.; Qian, W.; Zhang, X.; Wang, H.; Ye, K.; Bai, Y.; Zhou, G. Prevalence, genetic diversity and antimicrobial resistance of Listeria monocytogenes isolated from ready-to-eat meat products in Nanjing, China. Food Control. 2015, 50, 202–208. [Google Scholar] [CrossRef]
- Sepahvand, A.; Studzińska-Sroka, E.; Ramak, P.; Karimian, V. Usnea sp.: Antimicrobial potential, bioactive compounds, ethnopharmacological uses and other pharmacological properties; a review article. J. Ethnopharmacol. 2021, 268, 113656. [Google Scholar] [CrossRef]
- Wethalawe, A.N.; Alwis, Y.V.; Udukala, D.N.; Paranagama, P.A. Antimicrobial compounds isolated from endolichenic fungi: A review. Molecules 2021, 26, 3901. [Google Scholar] [CrossRef] [PubMed]
- Ahmed, M.Z.; Rao, T.; Khan, N.A.; Aslam, M.; Pane, Y.S. Antimicrobial Activities of Lichens. In Chemistry, Biology and Pharmacology of Lichen; Kumar Das, A., Sharma, A., Kathuria, D., Ansari, M.J., Bhardwaj, G., Eds.; John Wiley & Sons Ltd.: Hoboken, NJ, USA, 2024; Chapter 13; pp. 169–191. [Google Scholar] [CrossRef]
- Friedl, T.; Büdel, B. Lichen Biology, 2nd ed.; Arizona State University: Tempe, AZ, USA, 2008. [Google Scholar]
- Galloway, D.J. Global Environmental Changes: Lichens and Chemistry. Bibl. Lichenol. 1993, 53, 87–95. [Google Scholar]
- Schweiger, A.H.; Ullmann, G.M.; Nürk, N.M.; Triebel, D.; Schobert, R.; Rambold, G. Chemical properties of key metabolites determine the global distribution of lichens. Ecol. Lett. 2022, 25, 416–426. [Google Scholar] [CrossRef] [PubMed]
- Huneck, S.; Yoshimura, I. Identification of Lichen Substances; Springer: Berlin/Heidelberg, Germany, 1996. [Google Scholar]
- Quilhot, W.; Rubio, C.; Fernandes, E. Lichen product. In Biotechnology Secondary Metabolites Plants and Microbes; Ramawat, K.G., Merillon, J.M., Eds.; Taylor & Francis Group: Boca Raton, FL, USA, 2007; Chapter 14; pp. 391–415. [Google Scholar]
- Stocker-Wörgötter, E. Metabolic diversity of lichen-forming ascomycetous fungi: Culturing, polyketide and shikimate metabolite production, and PKS genes. Nat. Prod. Rep. 2008, 25, 188–200. [Google Scholar] [CrossRef] [PubMed]
- Molnára, K.; Farkasb, E. Current Results on Biological Activities of Lichen Secondary Metabolites: A Review. Z Naturforsch C. J. Biosci. 2010, 65, 157–173. [Google Scholar] [CrossRef]
- Müller, K. Pharmaceutically relevant metabolites from lichens. Appl. Microbiol. Biotechnol. 2001, 56, 9–16. [Google Scholar] [CrossRef]
- Russo, A.; Piovano, M.; Lombardo, L.; Garbarino, J.; Cardile, V. Lichen metabolites prevent UV light and nitric oxide-mediated plasmid DNA damage and induce apoptosis in human melanoma cells. Life Sci. 2008, 83, 468–474. [Google Scholar] [CrossRef] [PubMed]
- Zambare, V.P.; Christopher, L.P. Biopharmaceutical potential of lichens. Pharm. Biol. 2012, 50, 778–798. [Google Scholar] [CrossRef] [PubMed]
- Poulsen-Silva, E.; Otero, M.C.; Diaz-Cornejo, S.; Atala, C.; Fuentes, J.A.; Gordillo-Fuenzalida, F. Secondary metabolites of lichens: The untapped biomedical and pharmaceutical potential of antimicrobial molecules. Fungal Biol. Rev. 2025, 51, 100410. [Google Scholar] [CrossRef]
- Kosanić, M.; Ranković, B. Antioxidant and antimicrobial properties of some lichens and their constituents. J. Med. Food. 2011, 14, 1624–1630. [Google Scholar] [CrossRef] [PubMed]
- Manojlović, N.; Ranković, B.; Kosanić, M.; Vasiljević, P.; Stanojković, T. Chemical composition of three Parmelia lichens and antioxidant, antimicrobial and cytotoxic activities of some their major metabolites. Phytomedicine 2012, 19, 1166–1172. [Google Scholar] [CrossRef]
- Micheletti, A.C.; Honda, N.K.; Ravaglia, L.M.; Matayoshi, T.; Spielmann, A.A. Antibacterial potencial of 12 lichen species. An. Acad. Bras. Cienc. 2021, 93. [Google Scholar] [CrossRef] [PubMed]
- Galloway, D.J. Studies in Pseudocyphellaria (lichen) III. The South America Species; Bibliotheca Lichenologica, No. 46. Berlin & Stuttgart: J. Cramer. Lichenologist 1992, 46, 101–102. [Google Scholar]
- Quilhot, W.; Cuellar, M.; Díaz, R.; Riquelme, F.; Rubio, C. Lichens of Aisen, Southern Chile Líquenes de Aisén, sur de Chile. Gayana Botánica 2012, 69, 57–87. [Google Scholar] [CrossRef]
- Al-Nasiry, S.; Geusens, N.; Hanssens, M.; Luyten, C.; Pijnenborg, R. The use of Alamar Blue assay for quantitative analysis of viability, migration and invasion of choriocarcinoma cells. Hum. Reprod. 2007, 22, 1304–1309. [Google Scholar] [CrossRef]
- Uruén, C.; Chopo-Escuin, G.; Tommassen, J.; Mainar-Jaime, R.C.; Arenas, J. Biofilms as Promoters of Bacterial Antibiotic Resistance and Tolerance. Antibiotics 2020, 10, 3. [Google Scholar] [CrossRef]
- Tran, N.N.; Morrisette, T.; Jorgensen, S.C.J.; Orench-Benvenutti, J.M.; Kebriaei, R. Current therapies and challenges for the treatment of Staphylococcus aureus biofilm-related infections. Pharmacother. J. Hum. Pharmacol. Drug Ther. 2023, 43, 816–832. [Google Scholar] [CrossRef] [PubMed]
- Yang, Y.; Park, S.-Y.; Nguyen, T.T.; Yu, Y.H.; Van Nguyen, T.; Sun, E.G.; Udeni, J.; Jeong, M.-H.; Pereira, I.; Moon, C.; et al. Lichen Secondary Metabolite, Physciosporin, Inhibits Lung Cancer Cell Motility. PLoS ONE 2015, 10, e0137889. [Google Scholar] [CrossRef] [PubMed]
- Taş, İ.; Han, J.; Park, S.-Y.; Yang, Y.; Zhou, R.; Gamage, C.D.; Van Nguyen, T.; Lee, J.-Y.; Choi, Y.J.; Yu, Y.H.; et al. Physciosporin suppresses the proliferation, motility and tumourigenesis of colorectal cancer cells. Phytomedicine 2019, 56, 10–20. [Google Scholar] [CrossRef] [PubMed]
- Taş, İ.; Varlı, M.; Son, Y.; Han, J.; Kwak, D.; Yang, Y.; Zhou, R.; Gamage, C.D.; Pulat, S.; Park, S.-Y.; et al. Physciosporin suppresses mitochondrial respiration, aerobic glycolysis, and tumorigenesis in breast cancer. Phytomedicine 2021, 91, 153674. [Google Scholar] [CrossRef] [PubMed]
- Karagoz, Y.; Karagoz, B.O. Lichens in Pharmacological Action: What Happened in the Last Decade? Eurasian J. Med. 2022, 54, S195–S208. [Google Scholar] [CrossRef]
- European Committee for Antimicrobial Susceptibility Testing (EUCAST) of the European Society of Clinical Microbiology and Infectious Diseases (ESCMID). Determination of minimum inhibitory concentrations (MICs) of antibacterial agents by broth dilution. Clin. Microbiol. Infect. 2003, 9, 9–15. [Google Scholar] [CrossRef]
- Herigstad, B.; Hamilton, M.; Heersink, J. How to optimize the drop plate method for enumerating bacteria. J. Microbiol. Methods 2001, 44, 121–129. [Google Scholar] [CrossRef] [PubMed]
- Araya, N.; Leiva-Soto, M.A.; Bruna, M.V.; Castro-Munoz, A.; Behrend-Keim, B.; Moraga-Espinoza, D.; Bahamondez-Canas, T.F. Formulation of water-soluble Buddleja globosa Hope extracts and characterization of their antimicrobial properties against Pseudomonas aeruginosa. Front Pharmacol. 2022, 13, 921511. [Google Scholar] [CrossRef] [PubMed]

Disclaimer/Publisher’s Note: The statements, opinions and data contained in all publications are solely those of the individual author(s) and contributor(s) and not of MDPI and/or the editor(s). MDPI and/or the editor(s) disclaim responsibility for any injury to people or property resulting from any ideas, methods, instructions or products referred to in the content. |
© 2025 by the authors. Licensee MDPI, Basel, Switzerland. This article is an open access article distributed under the terms and conditions of the Creative Commons Attribution (CC BY) license (https://creativecommons.org/licenses/by/4.0/).
Share and Cite
Rubio, C.; Ramírez, J.; Weinstein-Oppenheimer, C.; Bahamondez-Canas, T.F.; Quiñones, N. Isolation, Chemical Characterization, and Antimicrobial Activity of Secondary Metabolites from Pseudocyphellaria faveolata. Molecules 2025, 30, 1368. https://doi.org/10.3390/molecules30061368
Rubio C, Ramírez J, Weinstein-Oppenheimer C, Bahamondez-Canas TF, Quiñones N. Isolation, Chemical Characterization, and Antimicrobial Activity of Secondary Metabolites from Pseudocyphellaria faveolata. Molecules. 2025; 30(6):1368. https://doi.org/10.3390/molecules30061368
Chicago/Turabian StyleRubio, Cecilia, Javiera Ramírez, Caroline Weinstein-Oppenheimer, Tania F. Bahamondez-Canas, and Natalia Quiñones. 2025. "Isolation, Chemical Characterization, and Antimicrobial Activity of Secondary Metabolites from Pseudocyphellaria faveolata" Molecules 30, no. 6: 1368. https://doi.org/10.3390/molecules30061368
APA StyleRubio, C., Ramírez, J., Weinstein-Oppenheimer, C., Bahamondez-Canas, T. F., & Quiñones, N. (2025). Isolation, Chemical Characterization, and Antimicrobial Activity of Secondary Metabolites from Pseudocyphellaria faveolata. Molecules, 30(6), 1368. https://doi.org/10.3390/molecules30061368

